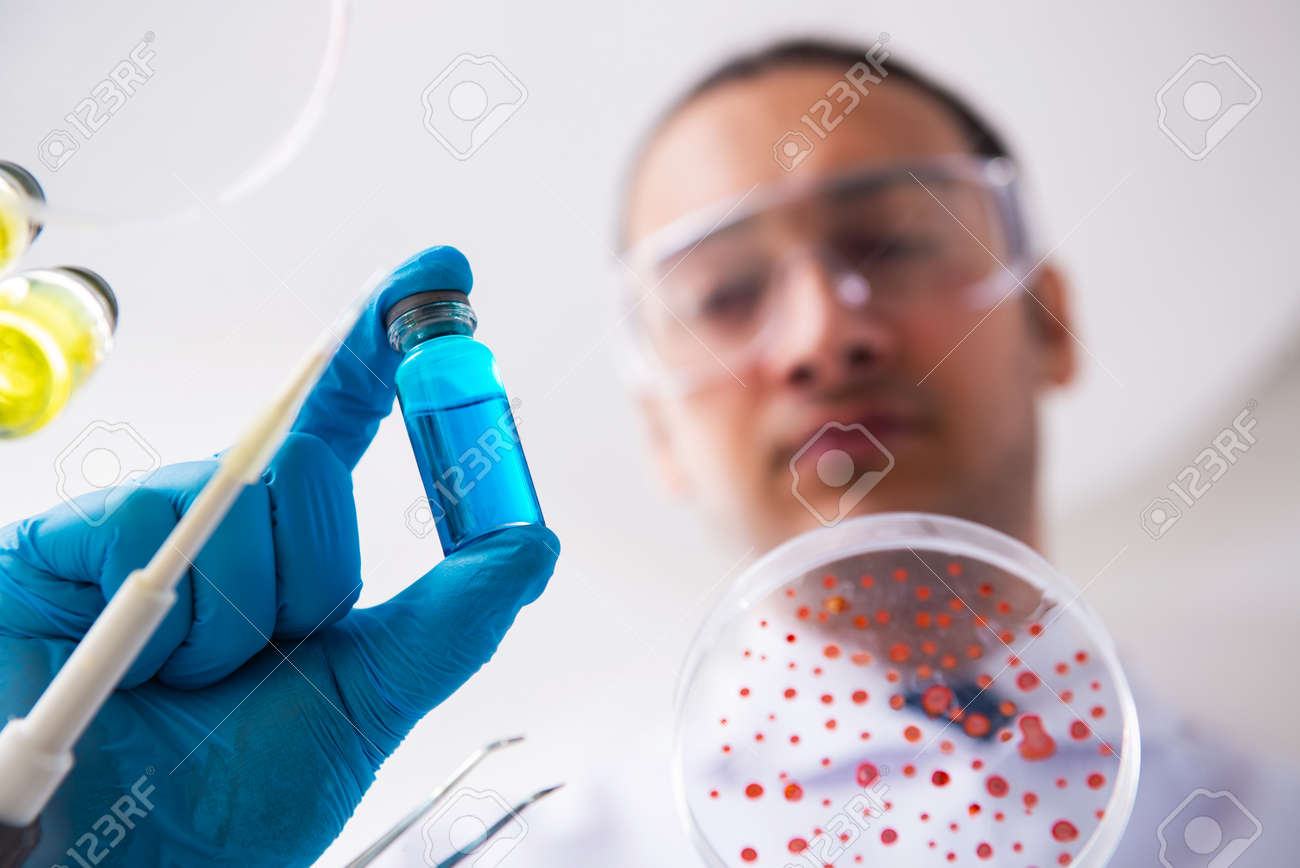
etiam-dictum-ipsum-a-felis

Download
Close
Автор:
id:
Ключевые слова:
analyzing, antibiotic, biochemical, biochemist, biochemistry, biology, biotechnology, blood, bottle, chemical, chemist, chemistry, coronavirus, covid19, discovery, dish, doctor, epidemic, experiment, experimenting, flu, glassware, health, healthcare, lab, laboratory, looking, medical, medicine, pandemic, petri, pharmaceutical, pharmacology, pharmacy, research, researcher, sample, sars, scientific, scientist, student, synthesis, test, testing, vaccination, vaccine, virology, virus,





